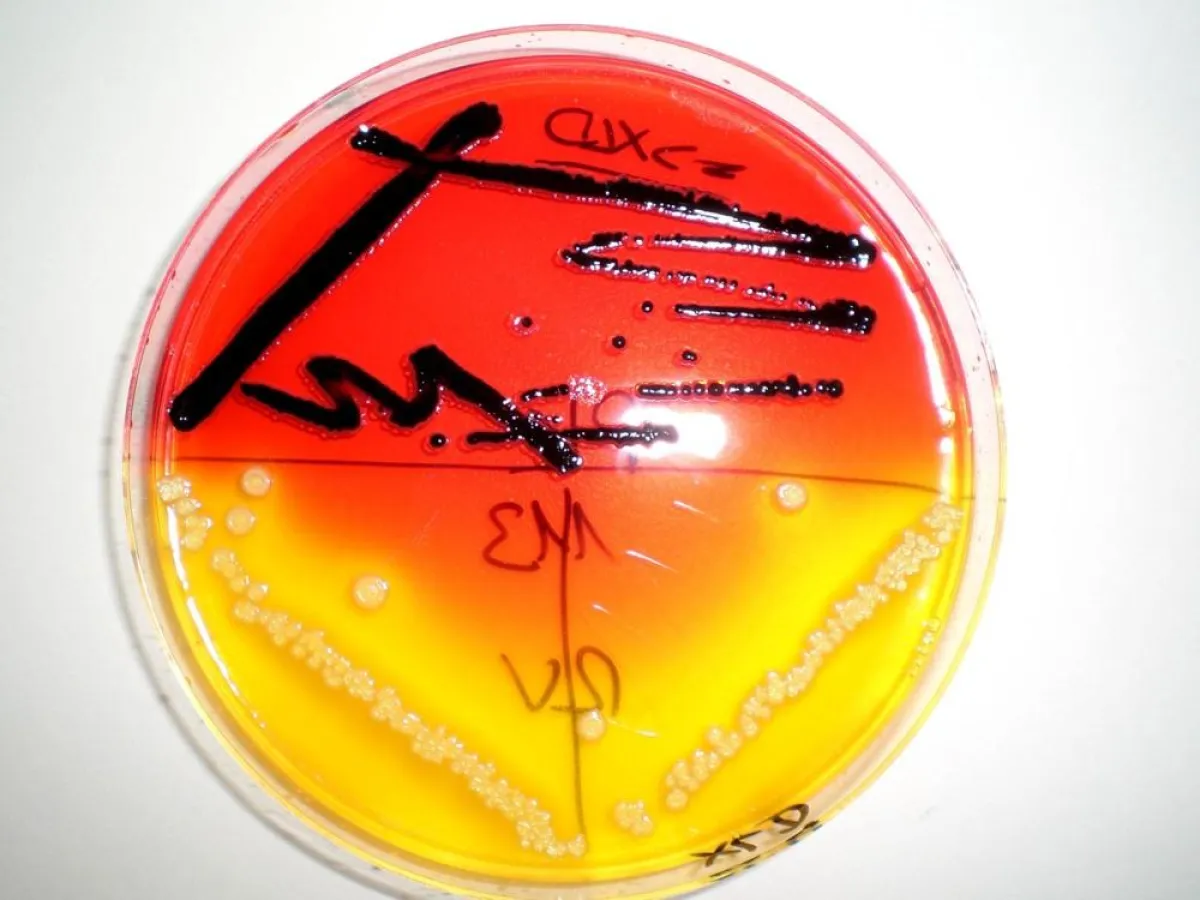

(openPR) Die europäische Leitmesse für Biotechnologie BIOTECHNICA in Hannover präsentiert im Oktober einen neuen Schwerpunkt: Lebensmittelbiotechnologie.
Die Möglichkeiten, die der Lebensmittelindustrie damit offen stehen, erstrecken sich nicht nur auf schnelle und hochsensitive Nachweisverfahren. Bereits bei der Produktion von Aromen oder Zusatzstoffen spielt die Biotechnologie eine große Rolle. Auch im Zusammenhang mit Konservierungsmethoden auf biologischer Basis gibt es Neuentwicklungen.
Die Deutsche Messe AG hat für Ihr Schwerpunktthema einen besonderen Ausstellungbereich ausgewiesen und veranstaltet ein Symposium zum Thema. "Biotechnological Innovation in Food" unter der Leitung von Prof. Dr. Klaus-Dieter Jany (CEF-Panel der Europäischen Bbehörde für Lebensmittelsicherheit EFSA) wird in deutscher Sprache gehalten. Neben den Fachreferaten zu Detektionsthemen "Allergene", "Mykotoxine", "GVO", "Nanosensoren" und einem Referat über die Möglichkeit mithilfe von Bakterienviren (Bakteriophagen) biologisch zu konservieren, präsentieren verschiedene Unternehmen Ihre Neuentwicklungen.
Highlight ist ein Mittagsvortrag von Udo Pollmer, Leiter des Europäischen Instituts für Lebensmittel- und Ernährungswissenschaften e.V. zum Thema "Welche Imageprobleme hat die Biotechnologie und wie kann sie damit umgehen?"
Teilnehmer des vom Bund für Lebensmittelrecht und Lebensmittelkunde BLL empfohlenen Symposiums können in der Mittagspause die Themen life auf der Messe komplettieren.
Programm: http://bit.ly/ntHiZE
Presseinformation
Lebensmittelbiotechnologie für mehr Lebensmittelsicherheit

Diese Pressemeldung wurde auf openPR veröffentlicht.
Verantwortlich für diese Pressemeldung:MicroMol GmbH
Abteilung Food Production Quality Service FPQS
Hedwigstr. 2-8
D-76199 Karlsruhe
Kontakt: Dr. Andrea Dreusch
Fon: +49 721 941 521 3
Fax: +49 721 941 521 4
mail:
web: www.FPQS.de
Abteilung Food Production Quality Service FPQS
Hedwigstr. 2-8
D-76199 Karlsruhe
Kontakt: Dr. Andrea Dreusch
Fon: +49 721 941 521 3
Fax: +49 721 941 521 4
mail:
web: www.FPQS.de
Über das Unternehmen
Die MicroMol GmbH vereint akkreditiertes Labor und Beratung. Seit 1996 bietet das unternehmergeführte Institut besten Service und persönliche Ansprechpartner. Validierungsstudien in Design und Ausführung und die Kombination von mikrobiologischen und molekularbiologischen, von immunochemischen und zellbiologischen Methoden sind eine Spezialität.
Das angeschlossene weltweit arbeitende Expertennetzwerk FPQS vereint die erfahrensten Berater und Auditoren der verschiedenen Lebensmittelsparten.
Das angeschlossene weltweit arbeitende Expertennetzwerk FPQS vereint die erfahrensten Berater und Auditoren der verschiedenen Lebensmittelsparten.
Pressebericht „Lebensmittelbiotechnologie für mehr Lebensmittelsicherheit“ bearbeiten oder mit dem "Super-PR-Sparpaket" stark hervorheben, zielgerichtet an Journalisten & Top50 Online-Portale verbreiten:
Disclaimer: Für den obigen Pressetext inkl. etwaiger Bilder/ Videos ist ausschließlich der im Text angegebene Kontakt verantwortlich. Der Webseitenanbieter distanziert sich ausdrücklich von den Inhalten Dritter und macht sich diese nicht zu eigen. Wenn Sie die obigen Informationen redaktionell nutzen möchten, so wenden Sie sich bitte an den obigen Pressekontakt. Bei einer Veröffentlichung bitten wir um ein Belegexemplar oder Quellenennung der URL.
Weitere Mitteilungen von FPQS der MicroMol GmbH


IFS Food Store - Lebensmittelsicherheit im Handel
Die Kontrolle der Lebensmittelsicherheit am Punkt der Abgabe an den Verbraucher ist ein wichtiges Instrument des Risikomanagements. Multiple Fehlerquellen können auch in einem modernen Supermarkt abgestellt werden. Neben der grundlegenden Hygiene ist zum Beispiel die Temperaturkontrolle in den Kühleinrichtungen nötig, um die Haltbarkeit der Produkte nicht zu gefährden.Aussortieren beim Obst und Gemüse oder MHD-Kontrolle sind wichtige Maßnahmen, um die Produktsicherheit zu gewährleisten.Der neue Zertifizierungsstandard IFS Food Store aus der I…


7. Karlsruher Lebensmittelsymposium
Lebensmittelsicherheit ist immer eine Funktion der Mikrobiologie, denn neben den Fremdkörperkontaminationen sind es Verunreinigungen mit Mikroorganismen, die während der Produktion vermieden werden müssen.
Das Karlsruher Lebensmittelsymposium greift 2013 wieder diesen Schwerpunkt auf, führt ihn aber fort in die Bereiche Konservierung und Frische und schließlich in die Sensorik. Denn für den Verbraucher ist der Geschmack zunächst das Wichtigste. Er setzt darauf, dass die Lebensmittel in jedem Fall sicher sind. Wer ergänzend zu diesen Themen w…
Das könnte Sie auch interessieren:


CARTOFLEX erfolgreich im Zertifizierungsmarathon
… Jahren implementierten Managementsysteme DIN EN ISO 9001 Qualitätsmanagement und DIN EN ISO 14001 Umweltmanagement wurden um die DIN EN ISO 22000 Lebensmittelsicherheit erweitert.
Gesetzgeber, Kunden und Verbraucher fordern in zunehmendem Maße Garantien für gleichbleibend hohe Qualität und hygienische Herstellungsverfahren ihrer Nahrungsmittel. Renommee …


Für Lebensmittelsicherheit - im Kompetenzzentrum Bio-Security vollausgestattete Labore mieten
Unser Ziel ist es die Lebensmittelsicherheit, die Lebensmittelqualität, die Lebensmittelentwicklung und den Verbraucherschutz zu verbessern. Durch eine Verbesserung der Lebensmittelsicherheit, der Lebensmittelqualität, der Lebensmittelentwicklung und des Verbraucherschutzes möchten wir den Lebensmittelkonsumenten nachhaltig unterstützten.
Dies funktioniert …

Die ROC Behörde für Verbraucherschutz und Lebensmittelsicherheit läuft auf Hochtouren
Die auf Kabinettsebene angesiedelte Behörde für Verbraucherschutz und Lebensmittelsicherheit (OFS) nahm ihren Betrieb am 20. Oktober 2014 auf; ein Schritt, der das Engagement der Regierung zur Stärkung nationaler Lebensmittelsicherheit und ressortübergreifender Überwachungsmaßnahmen unterstreicht.
Bestehend aus leitenden Mitarbeitern des Landwirtschaftsrates, …


Lebensmittelsicherheit ist machbar
Zweitägiges Karlsruher Lebensmittelsymposium brachte Produktion, Handel, Wissenschaft und Politik zum Lernen und zum Dialog zusammen. Die wichtigen Bausteine für Lebensmittelsicherheit und Verbraucherschutz waren am 23. und 24.11. Thema beim 8. Karlsruher Lebensmittelsymposium. Hundert Teilnehmende aus dem gesamten deutschsprachigen Raum hörten Vorträge …


Marburger Symposium: Globaler Lebensmittelhandel, globale Risiken?
Die Lebensmittelsicherheit im globalen Handel ist das Thema des 4. Marburger zum Lebensmittelrecht, das am 19. November 2010 in Marburg stattfindet. Fachreferenten aus der Lebensmittelwirtschaft, der Überwachung und der Wissenschaft fächern das Themenspektrum breit auf: Behandelt werden neben den Standards der World Trade Organisation (WTO), der Novel …


Lebensmittel - Biotechnologie
… möglicherweise gefährlich.
Dass Biotechnologie im Gegenteil Lebensmittel sicherer machen kann, möchte die Deutsche Messe AG im Rahmen ihres neuen Themenschwerpunktes Lebensmittelbiotechnologie zeigen. Mit großem Engagement haben die Verantwortlichen eine Sonderausstellung, ein Symposium, eine Pressekonferenz und öffentliche Vorträge zum Thema organisiert. …

Bioverfahrenstechnik und Lebensmittelbiotechnologie lernen voneinander
… Produktion, aber auch die Grenzen und Herausforderungen für Entwurf und Konstruktion neuer Labor-, Pilot- und Produktionsanlagen in der Bioverfahrenstechnik und Lebensmittelbiotechnologie aufgezeigt.
Ob bei der Herstellung pharmazeutischer Wirkstoffe oder der Nutzung nachwachsender Rohstoffe – biotechnologische Verfahren werden für die industrielle Produktion …


7. Karlsruher Lebensmittelsymposium
Lebensmittelsicherheit ist immer eine Funktion der Mikrobiologie, denn neben den Fremdkörperkontaminationen sind es Verunreinigungen mit Mikroorganismen, die während der Produktion vermieden werden müssen.
Das Karlsruher Lebensmittelsymposium greift 2013 wieder diesen Schwerpunkt auf, führt ihn aber fort in die Bereiche Konservierung und Frische und …


Lebensmittelsymposium
Lebensmittelsicherheit ist das zentrale Thema des zweitägigen Symposiums am 9. und 10.11.2017 in Offenburg. Das BAV Institut, Offenburg und das Labor MicroMol, Karlsruhe laden zu diesem Event gemeinsam ein. Die besten Referenten der Lebensmittelsparte fassen die aktuellen Themen in prägnanten Vorträgen zusammen. Mikrobielle Gefahren, Food Fraud (Lebensmittelverfälschung), …


Gesetze und Standards gegen Risiken in der Lebensmittelindustrie
White Paper von Sesotec hilft bei der Auswahl eines Lebensmittelsicherheitsstandards
Lebensmittelsicherheit ist einer der zentralen Aspekte der weltweiten Lebensmittelindustrie und Lebensmittelsicherheitsstandards sind die Eintrittskarten in viele Märkte. Zum einen hat jedes Land eigene gesetzliche Regelungen, zum anderen gibt es auch privatwirtschaftliche …
Sie lesen gerade: Lebensmittelbiotechnologie für mehr Lebensmittelsicherheit